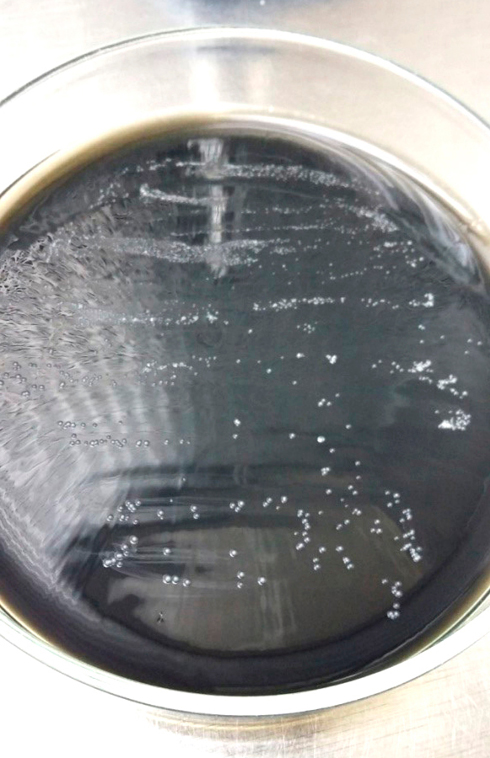

Artículos

Esta obra está bajo una Licencia Creative Commons Atribución-NoComercial 4.0 Internacional.
Recepción: 13 Enero 2021
Aprobación: 04 Junio 2021
Publicación: 01 Diciembre 2021
Resumen: Xylella fastidiosa está considerada plaga cuarentenaria de importancia global por el grave impacto económico y social que ocasiona en cultivos de importancia agrícola. El objetivo de este trabajo fue aislar y caracterizar cepas bacterianas y muestras vegetales infectadas con X. fastidiosa de plantas de olivo (Olea europaea L.) e implementar un sistema de diagnóstico serológico para su detección. Para la caracterización molecular se utilizó el sistema de tipificación multilocus de secuencias (MLST). Se logró el aislamiento de la bacteria desde olivo y se determinó que todos los materiales caracterizados corresponden a X. fastidiosa subespecie pauca ST69, un grupo genético solo presente en Argentina. Se elaboraron reactivos serológicos fundamentales para la puesta a punto de técnicas de diagnóstico. Con la técnica DAS ELISA se logró un sistema de diagnóstico rápido, robusto y económico, permitiendo resolver la ausencia de disponibilidad continua de reactivos serológicos específicos para X. fastidiosa.
Palabras clave: bacteria xilemática, MLST, antisuero, pruebas inmunológicas.
Abstract: Xylella fastidiosa is considered a quarantine pest of global significance due to the severe economic and social damage it causes on most valuable crops. The objective of this work was to isolate and characterize bacterial strains of infected with X. fastidiosa of olive (Olea europaea L.) samples and implement a serological diagnostic system for their detection. For the molecular characterization, the multilocus sequence typing system (MLST) was used. The isolation of the bacterium from the olive tree was achieved and it was determined that all materials characterized correspond to X. fastidiosa subsp. pauca ST69, a genetic subgroup that has been detected only in Argentina. An antiserum was produced and serological diagnosis systems were adjusted. A solid, fast and economical diagnostic method DAS ELISA system was achieved, solving the continuous lack of availability of serological reagents for X. fastidiosa.
Keywords: xylem bacterium, MLST, antiserum, immune tests.
INTRODUCCIÓN
Xylella fastidiosa (Wells et al., 1987) es una bacteria fitopatógena de la familia Xanthomonadaceae (Gammaproteobacteria) que coloniza y se multiplica en los vasos xilemáticos de algunas especies vegetales y en el intestino anterior de insectos de las familias Cicadellidae y Cercopidae, los que se alimentan de la savia xilemática (Sicard et al., 2018). Dentro del grupo de las bacterias “fastidiosas” es considerada la de mayor relevancia por las pérdidas económicas que ocasiona en determinados cultivos perennes de interés agrícola como vid, cafeto, olivo, naranjo, duraznero y almendro, entre otros, y por su distribución geográfica en el mundo (European Commission, 2018). X. fastidiosa es capaz de traslocarse y multiplicarse en un amplio rango de hospedantes, ha sido detectada en más de 600 especies, abarcando no solo de interés agrícola, sino también ornamentales y malezas (Phytoma, 2020). Es una especie bacteriana genéticamente diversa, y actualmente se consideran las siguientes subespecies: fastidiosa, pauca, multiplex, sandyi, morus y tashke (Danancé et al., 2019; Schaad et al., 2004 y Schuenzel et al., 2005).
Nunney et al. (2014) mencionan que X. fastidiosa es nativa del continente americano; sin embargo, en octubre del 2013 se detectó en olivares de la región de Apulia al sureste de Italia, siendo esta la primera cita del patógeno en la Unión Europea (Carlucci et al., 2013; Loconsole et al., 2014; Saponari et al., 2013; Saponari et al., 2014). Más recientemente, ha sido detectada en España, Francia y norte de Portugal (CAGPDS-JA, 2020; Denancé et al., 2017; Gutiérrez Hernández y García, 2018; Landa et al., 2019; Morente et al., 2018).
Si bien en Argentina desde la década de 1990 X. fastidiosa está presente en almendros (Nome et al., 1992) y naranjos (Brlansky et al., 1991) fue recién a fines del 2013 que se detectó en plantaciones tradicionales de olivo de la provincia de La Rioja (Haelterman et al., 2015; Roca et al., 2014). Posteriormente, fue hallada en las provincias de Córdoba (Tolocka et al., 2014) y Catamarca (Von Baczko et al., 2017). En montes de olivo, el síntoma observado es un marcado declinamiento de las plantas, principalmente en los olivares tradiciones de más de 50 años de edad, que se va acentuado con los años, siendo Arauco la variedad más afectada. Además, se observan ramas con hojas secas en el extremo de las copas y hojas con una coloración verde seco opaca, con frecuencia con el ápice necrosado (“punta de flecha”) detectado por lo general en la base de las ramas afectadas que no se distribuyen uniformemente en la copa de los árboles (figuras 1A y 1B).

Figura 1
íntomas ocasionados por Xylella fastidiosa en olivo. A. Planta de olivo tradicional var. Arauco de la zona de La Merced, localidad de Aimogasta (La Rioja), mostrando síntomas avanzados de la enfermedad. B. Detalle de la necrosis apical en hojas denominada “Punta de Flecha (PF)”.
Esta situación se observa principalmente en la localidad de Aimogasta, provincia de La Rioja, con gran mortandad de plantas, y en menor medida en las otras regiones olivícolas, posiblemente porque predomina la variedad Arauco, muy apreciada en nuestro país por sus atributos organolépticos y doble propósito, además de ser la única variedad representante de Argentina en el Catálogo Mundial de Variedades de Olivo (Barranco Navero et al., 2000; Tacchini, 2011).
Actualmente una de las metodologías utilizadas para la caracterización taxonómica en esta bacteria es el sistema de tipificación multilocus de secuencias o “Multilocus Sequence Typing” (MLST) (Denancé et al., 2017; Nunney et al., 2013; Yuan et al., 2010) que permite definir subespecies y asignar el grupo genético o tipo de secuencia (SequenceType-ST) a cada aislamiento. Este sistema de tipificación está basado en el análisis comparativo de las secuencias de siete genes constitutivos que están distribuidos por todo el cromosoma bacteriano, definiendo un perfil alélico único para cada grupo genético o ST (Elbeaino et al., 2014; Landa et al., 2017; Scally et al., 2005). Nuestro grupo de trabajo detectó previamente X. fastidiosa subsp. pauca ST69 en una muestra vegetal de olivo (Tolocka et al., 2017a) y ST78 en una cepa aislada a partir de almendro (Tolocka et al., 2017b).
La identificación de la bacteria a un nivel infraespecífico (por debajo de la categoría taxonómica especie) es esencial para comparar cepas presentes en diferentes zonas de estudio, aisladas en distintos momentos, determinando si representan una misma población bacteriana. El conocimiento de la subespecie a la que pertenecen las cepas aisladas permite comprender mejor la epidemiología causada por este patógeno y lograr una descripción adecuada de la estructura de la población y su dinámica (Cesbron et al., 2020). Para conocer la variabilidad existente dentro de las cepas de X. fastidiosa es necesario continuar con la detección de posibles variantes de la bacteria presente en los cultivos de olivos de nuestro país.
X. fastidiosa es una bacteria difícil de aislar ya que se multiplica solamente en medios de cultivos enriquecidos y complejos. Debido a esta dificultad para su diagnóstico se emplean técnicas serológicas y moleculares. Las primeras son generalmente utilizadas para el monitoreo a gran escala por la simplicidad de la preparación de la muestra; mientras que las pruebas moleculares, al ser más sensibles, permiten confirmar la presencia del patógeno aún en bajas concentraciones en la planta (Loncosole et al., 2014). Actualmente en nuestro país se emplean reactivos serológicos comerciales importados, lo que podría disminuir la sensibilidad de las pruebas por estar elaborados con cepas de otros países. Esto genera la necesidad de contar con reactivos propios obtenidos a partir de cepas locales, para lo cual es fundamental lograr aislamientos nativos de la bacteria.
Por lo expuesto anteriormente, el objetivo de este trabajo fue aislar y caracterizar cepas y muestras vegetales infectadas con X. fastidiosa provenientes de olivo e implementar un sistema de diagnóstico serológico a partir de la elaboración de antisueros policlonales con cepas locales de la bacteria.
MATERIALES Y MÉTODOS
Aislamiento de X. fastidiosa a partir de olivo
Se realizaron aislamientos desde octubre de 2017 a mayo de 2018, empleando trozos de ramas del año, de 0,5-1 cm de diámetro, provenientes de dos plantas de olivo infectadas, procedentes de las zonas Tiro Federal ii (-28.57039º , -66.80264º ) y La Merced (-28.593236º , -66.790403º) (Aimogasta, La Rioja), corroboradas positivas para la bacteria por DAS ELISA (Clark y Adams, 1977) con reactivos Agdia y por PCR empleando los cebadores RST31/33 (Minsavage et al., 1994) y HL5/6 (Francis et al., 2006). El material vegetal fue desinfectado con etanol 70% durante 2 min, luego con hipoclorito de sodio 3% durante 3 min y se realizaron tres enjuagues con agua destilada estéril, realizando todo el proceso en cámara de flujo laminar (Cariddi et al., 2014). Posteriormente, se procedió a presionar las ramitas con una pinza sobre el medio de cultivo agar de extracto de levadura y carbón tamponado (BCYE) (Wells et al., 1981) en placas de Petri y se incubaron a 28 ºC .
Las placas fueron observadas regularmente hasta la aparición de colonias, confirmando su identidad mediante PCR con los cebadores mencionados previamente. Las colonias obtenidas fueron repicadas a otros medios de cultivo: Periwinkle Wilt (PW) (Davis et al., 1981a), Pierce Disease2 (PD2) (Davis et al., 1980) y Pierce Disease3 (PD3) (Davis et al., 1981b), e incubadas a 28 ºC para observar su crecimiento. Los cultivos bacterianos de las cepas aisladas se almacenaron en medio liquido BCYE con 30% de glicerol a -80 ºC .
Caracterización morfológica y molecular de X. fastidiosa
Para la identificación morfológica, se fijaron trozos de pecíolos de 3 x 2 mm a partir de hojas sintomáticas infectadas de olivo. Luego, se realizaron cortes ultrafinos del material incluido en resina de baja viscosidad (Spurr low viscocity) contrastados con acetato de uranilo 2% y citrato de plomo 0,7% pH 12, siguiendo el protocolo descripto por Kitajima y Nome (1999). Los preparados se observaron en un microscopio electrónico de transmisión Jeol JEM EXII (Jeol, Tokio, Japón) a magnificaciones de 10.000X y 250.000X.
Para la observación de las oclusiones en los vasos xilemáticos se efectuaron cortes a mano alzada de secciones de pecíolos de hojas sintomáticas, sometiendo el material a luz UV durante toda la noche. Las secciones se hidrataron en agua destilada, y posteriormente se tiñeron con una solución rojo de rutenio al 0,005% durante 10 minutos. Posteriormente, se enjuagaron en agua y se observaron en un microscopio Nikon Eclipse CS1 en modalidad de campo claro, a un aumento de 20X y 40X. Las imágenes se adquirieron mediante el software Nikon Elements.
Para la caracterización molecular de la bacteria, se utilizó el sistema de tipificación MLST en dos cepas denominadas OLI17A y AM2, aisladas de olivo (Aimogasta, La Rioja) y en muestras vegetales (CE1 y CATA1) provenientes de dos plantas infectadas de los dptos. Cruz del Eje (Córdoba) y Pomán (Catamarca), respectivamente.
La extracción de ADN se realizó a partir de extractos de plantas enfermas siguiendo el protocolo descripto por Murray y Thompson (1980), utilizando 100 mg de material vegetal. En el caso de las cepas se empleó suspensión de colonias. Luego, por PCR, se amplificaron por duplicado los siete genes involucrados en la tipificación (leuA, petC, malF, cysG, holC, nuoL y gltT) según Yuan et al. (2010), los productos fueron purificados usando el kit de purificación de PCR QIAquick (Qiagen), siguiendo lo descripto por el proveedor, y secuenciados en la Unidad de Genómica CICVYA-INTA-Castelar.
Las secuencias correspondientes de cada locus fueron editadas, alineadas y analizadas mediante los programas bioinformáticos Chromas Lite 2.0.1 (http://technelysium.com.au/wp/chromas/) y BioEdit versión 7.2 (https://bioedit.software.informer.com/). Posteriormente, se realizó la confrontación de las secuencias obtenidas con las secuencias concatenadas de los siete loci presentes en la base de datos de MLST de Xylella fastidiosa (https://pubmlst.org/xfastidiosa/) determinando su ST.
El árbol filogenético se construyó a partir del alineamiento de las secuencias realizado con Clustal W (Tompson et al., 1994), utilizando el método Neighbor-joining de Saitou y Nei (1987) con un valor de bootstrap de 1000 repeticiones (Felsenstein, 1985) mediante el programa MEGA versión 6.0 (Tamura et al., 2013). En el análisis se incluyeron las STs de X. fastidiosa subsp. pauca más relacionadas con las STs en estudio. Todos los datos de MLST se encuentran disponibles en la base de datos mencionada.
Producción y titulación de antisueros específicos para X. fastidiosa a partir de un aislamiento local
En la elaboración del antisuero, debido a la baja tasa de multiplicación de las cepas aisladas provenientes de olivo, se utilizó un aislamiento obtenido anteriormente a partir de almendro, debido a su mayor velocidad de crecimiento. Este aislamiento denominado ALM4 fue caracterizado como X. fastidiosa subsp. pauca ST78.
Para la obtención del inóculo se agregó a los cultivos en placa NaCl estéril al 0,85% y la suspensión bacteriana se trasvasó a microtubos, los que se centrifugaron a 9.300 g durante 5 min. El precipitado obtenido fue resuspendido en la misma solución, se ajustó su concentración a 108 UFC/ml y se conservó en alícuotas a -20 ºC .
Para la obtención del antisuero se inmunizó una coneja de la raza Nueva Zelanda con la suspensión bacteriana emulsionada con igual volumen de adyuvante incompleto de Freund (Sigma Aldrich, EUA). Se realizaron ocho inmunizaciones y el esquema de inyecciones y obtención de sueros fue el siguiente: primera inoculación con 4 inyecciones subcutáneas de 200 µl en el lomo y dos intramusculares de 500 µl en las patas traseras; segunda y tercera: a los 15 y 30 días de la primera inoculación aplicando únicamente inyecciones intramusculares de 500 µl en cada pata. La primera obtención de suero se realizó a los 21 días de la tercera inmunización. Cinco días después se inmunizó nuevamente en forma intramuscular y se sangró a los 15 días (2.a sangría), repitiendo este paso cuatro veces.
Se compararon los seis antisueros obtenidos (AsXf 1-6) mediante ELISA indirecto en placa (PTA ELISA, “Plate Trapped Antigen - Enzyme Linked Immunosorbent Assay”) (Lommel et al., 1982) en diluciones 1/500, 1/1000 y 1/2000 frente a suspensiones bacterianas (108, 107, 106 UFC/ml), extracto de planta sana y enferma de olivo (1/10) y control positivo Agdia Inc-SRA 34503, diluidos en tampón de cobertura.
El antisuero seleccionado fue titulado a través de la técnica Dot Blot en membrana de nitrocelulosa (Fuente Delgado, 1990 y Hammond y Jordan, 1990). Durante la puesta a punto de la técnica se observaron reacciones inespecíficas en planta sana por lo que se le realizó una extracción con cloroformo a los extractos vegetales en relación 2:1 v/v extracto:cloroformo empleando diluciones de 1/80000 a 1/1280000 contra extractos de planta sana y enferma de olivo, suspensión de X. fastidiosa (de olivo y almendro) y tampón de extracción.
Implementación de la técnica serológica DAS ELISA para diagnóstico
En la implementación del antisuero para su uso en diagnóstico se procedió a poner a punto la técnica de DAS ELISA, para la cual se purificó la inmunoglobulina G (IgG) llevándola a una concentración de 1 mg/ml. Luego, con fracciones de IgG se elaboraron conjugados enzimáticos (Ball et al., 1990), con fosfatasa alcalina (Sigma-Aldrich, St. Louis, MO, EUA) (MacKenzie, 1990). Se utilizaron combinaciones de diluciones de IgG y conjugado (1/200, 1/500 y 1/1000), frente a suspensiones de X. fastidiosa subsp. pauca AM2 (106, 105 y 104 UFC/ml) de olivo diluidas en tampón de extracción y en extracto de testigos sanos y enfermo 1/10 y 1/30 (p/v). Las mismas muestras se repitieron utilizando los reactivos Agdia siguiendo su protocolo de laboratorio. Posteriormente, se determinó la especificidad del suero confrontándolo a otras especies de bacterias patógenas de plantas (Xanthomonas citri pv. citri, Pseudomonas fluorescens, P. savastanoi, Acidovorax sp.) en suspensiones de 106 UFC/ml.
Para cada suspensión bacteriana se realizó un análisis de varianza a través de modelos lineales mixtos para comparar los niveles de absorbancia entre los diferentes reactivos. Los sistemas quedaron definidos como la combinación de los factores reactivos (Agdia y AsXf4), las concentraciones del extracto de planta sana (1/10 y 1/30 (p/v), las tres concentraciones bacterianas probadas (104, 105, 106 UFC/ml) y dos tiempos de lecturas (60 y 120 min).
RESULTADOS
Se logró aislar la bacteria a partir de las dos plantas analizadas, obteniendo las cepas OLI17A, proveniente de Tiro Federal ii y AM2, de La Merced, en diciembre de 2017 y mayo de 2018, respectivamente. Las colonias de ambos aislamientos se observaron a partir de los 30 días posteriores de la siembra en el medio de cultivo BCYE (figura 2); presentando aspecto translúcido, convexo y opalescente, algunas con márgenes enteros y otra levemente ondulados. No se observó crecimiento de estas cepas bacterianas en ninguno de los otros medios de cultivo evaluados (PW, PD2 y PD3).
Figura 2
Colonias de la cepa OLI17A de Xylella fastidiosa en medio BCYE, aisladas desde olivo.
Caracterización morfológica y molecular de X. fastidiosa
En cortes ultrafinos para microscopía electrónica fue posible observar la presencia de la bacteria en muestras de olivo (figuras 3 A y B).

Figura 3.A.
Bacilos de Xylella fastidiosa presentes en vasos xilemáticos de hojas de olivo, observados por microscopía electrónica de Transmisión. 3.B. Detalles del bacilo a mayor aumento.
En los cortes de material vegetal se visualizaron células sin flagelos, en forma de bacilos rectos con la característica de la pared celular ondulada y dimensiones correspondientes a los bacilos pertenecientes a X. fastidiosa (Landa et al., 2017).
Mediante microscopía óptica de campo claro, en cortes de pecíolo de olivo, los vasos xilemáticos completamente diferenciados se observaron ocluidos (coloreados con rojo rutenio), no sucediendo lo mismo en las muestras de material vegetal sano (figuras 4 A y B).

Figura 4
Cortes transversales por vasos xilemáticos de pecíolos de hojas de olivo. A. taponamiento de los vasos en planta enferma con X. fastidiosa. B. vasos xilemáticos de planta sana.
La tipificación por MLST permitió determinar que las cepas OLI17A y AM2 aisladas, al igual que las detectadas en muestras de plantas infectadas (CE1 y CATA1), pertenecen a X. fastidiosa subespecie pauca ST69. En la figura 5 se muestra el análisis filogenético de las secuencias tipo (ST) caracterizadas en este trabajo con las STs de X. fastidiosa subsp. pauca más relacionadas. La secuencia tipo de olivo de nuestro país, se encuentra alejada del grupo genético ST53 de Italia y más cercana a la ST65 de Brasil.

Figura 5
Árbol filogenético de las secuencias tipo (ST) de X. fastidiosa subsp. pauca provenientes de diferentes hospedantes y países. Realizado a través del método Neighbor-Joining con el programa Mega versión 6.0. Los valores de bootstrap (1000 repeticiones) se indican en cada nodo. La barra indica número de sustituciones/nucleótidos.
Producción y titulación de antisueros específicos para X. fastidiosa a partir de un aislamiento local
Una vez finalizado el esquema de inmunización se obtuvieron seis antisueros de X. fastidiosa proveniente de almendro que fueron denominados AsXf1 a AsXf6. Los resultados del PTA ELISA determinaron que la mayor lectura de absorbancia del testigo enfermo se obtuvo con el AsXf4 en la dilución 1/2000, observándose aquí la mayor diferencia entre testigos sanos y enfermos.
La titulación del AsXf4 por Dot Blot mostró alta reacción específica frente a extractos de planta enferma de olivo y suspensión bacteriana aislada de almendro y olivo, y no reaccionó frente a extractos de planta sana, cuando las muestras fueron extraídas con cloroformo, siendo importante la incorporación de este paso en el protocolo. El suero reaccionó hasta la máxima dilución probada 1/1280000.
Implementación de la técnica serológica DAS ELISA para diagnóstico
El antisuero AsXf4 fue seleccionado para la puesta a punto de la técnica de DAS ELISA. Se eligió 1/200 como dilución de trabajo de la IgG y del conjugado debido a que mostró las mayores diferencias en valores de absorbancia entre los testigos sanos y enfermos. Se observó inhibición cuando se utilizó la planta enferma molida 1/10 (p/v), lo mismo sucedió con las suspensiones bacterianas diluidas 1/10 (v/v) con extracto de planta sana de olivo en AsXf4 y Agdia. A la hora de reacción fueron reconocidas todas las muestras analizadas con ambos reactivos en la concentración 106 UFC/ml. En 105 UFC/ml, los dos reactivos reconocieron las muestras solo en la dilución 1/30 (tabla 1).

Tabla 1
Respuesta de los reactivos AsXf4 y Agdia frente a diferentes concentraciones de X. fastidiosa y tiempos de lectura. Medias ajustadas y errores estándares para reactivos, tiempo de absorbancia y dilución del extracto. Medias con una letra común no son significativamente diferentes (p>0,05).
* Media estadísticamente diferente a la media de los testigos (0,09 para Agdia a los 120 minutos y 0,05 para Agdia a los 60 minutos. 0,02 para AsXf4 en ambos tiempos).
** Media estadísticamente diferente a dos veces la media de los testigos (0,18 para Agdia a los 120 minutos y 0,10 para Agdia a los 60 minutos. 0,04 para AsXf4 en ambos tiempos).
En dicha tabla se presentan para cada una de las concentraciones bacterianas las comparaciones de los dos sistemas. También se indica si las absorbancias de cada uno de los reactivos superaron los umbrales de detección. Se utilizaron dos criterios para definir los umbrales de detección: las absorbancias de la media y dos veces la media de los testigos sanos. A las dos horas de reacción, la concentración 106 UFC/ml siguió dando positivo con ambos reactivos, mientras que en la concentración bacteriana 105 AsXf4 reconoce las muestras solo en la dilución 1/30.
Ambos sistemas tienen el mismo comportamiento de reacción en relación con la detección del patógeno en la concentración 106 UFC/ml, difiriendo su respuesta en 105 UFC/ml. Se menciona que a las dos horas de reacción el AsXf4 en la dilución de extracto 1/30 es estadísticamente igual al comercial en ambas concentraciones bacterianas. La suspensión de X. fastidiosa 104 UFC/ml no fue reconocida por ninguno de los dos sistemas. Esta técnica serológica permitió detectar la presencia de X. fastidiosa en extractos de plantas de olivos y almendros en diluciones del patógeno de 105 y 106 UFC/ml.
Cuando se realizaron ensayos para probar la especificidad del AsXf4 enfrentándolo a otras bacterias patógenas de vegetales: X. citri pv. citri, P. fluorescens, P. savastanoi, Acidovorax sp., en diluciones 106 UFC/ml, no se obtuvieron reacciones cruzadas (resultados no mostrados). Un ensayo similar se realizó en el laboratorio de bacteriología del Centro de Protección Vegetal y Biotecnología del Instituto Valenciano de Investigaciones Agrarias (IVIA) de Valencia, España, donde enfrentaron dos cepas de X. arboricola pv. pruni y una cepa de Erwinia amylovora con el AsXf4 presentando solo una leve reacción cruzada con E. amylovora. Según EPPO (2018), el reactivo comercial Agdia tiene reacción cruzada con P. syringae pv. syringae y X. arboricola pv. pruni.
DISCUSIÓN Y CONCLUSIONES
X. fastidiosa es una bacteria muy difícil de erradicar (Catalano et al., 2019), por lo que todos los esfuerzos deben ir dirigidos a la prevención de su introducción en nuevas áreas. Se deben desarrollar estrategias orientadas hacia la prevención y el control de la enfermedad con el fin de disminuir su impacto en la producción.
Este es el primer estudio en Argentina donde se reporta el aislamiento exitoso de X. fastidiosa subsp. pauca a partir de plantas de olivo y su identificación por MLST confirma el grupo genético ST69 en este hospedante, el cual fue detectado en trabajos previos en cítricos y olivo (Coletta-Filho et al., 2017; Tolocka et al., 2017a; Tolocka et al., 2017c). Este ST no ha sido reportado fuera de Argentina hasta el presente.
Si bien en el aislamiento de la bacteria se debe tener en cuenta la época del año en que se realiza, dado que las condiciones ambientales influyen en la concentración de la misma en la planta (Landa et al., 2017), los aislamientos realizados a partir del material procedente de dos diferentes muestreos (diciembre para OLI17A y mayo para AM2) fueron exitosos.
Estudios realizados en Italia por De Benedictis et al. (2017) mostraron un mayor número de oclusiones en las variedades de olivo más susceptibles a X. fastidiosa, como son los cv. Ogliorola y Cellina di Nardó, comparado al cv. Leccino, el cual se comporta como más tolerante. Estas oclusiones están constituidas por tilosas y pectinas producidas por las respuestas fisiológicas de la planta ante la infección, las cuales no pueden diferenciarse de los posibles agregados producidos por la bacteria. En la enfermedad de Pierce (Pierce disease, PDB) en vid se ha comprobado que la planta ocluye sus propios vasos como una respuesta fisiológica para contener la propagación bacteriana (Fritschi et al., 2008). Si bien De Benedictis et al. (2017) no consideran esta respuesta como un marcador de tolerancia/resistencia a la enfermedad, podría ser tenida en cuenta en ensayos de búsqueda de cultivares tolerantes a la bacteria.
Si bien las muestras analizadas de olivo de diferentes zonas del país pertenecen a un mismo ST, no se descarta la posibilidad de que se presenten otras variantes genéticas como ocurre en los cítricos de Brasil, donde se han encontrado cinco STs diferentes (Coletta-Filho et al., 2017). Las STs de X. fastidiosa caracterizadas en olivos provenientes de la región del noroeste argentino (NOA) y las de naranjos del noreste argentino (NEA) son iguales, constituyendo un riesgo potencial de transmisión para las plantaciones citrícolas de la región del NOA, donde aún no ha sido detectada la presencia de esta bacteria.
El análisis filogenético de las secuencias analizadas mostró que la ST69 está más relacionada genéticamente con la ST65 de cítricos que con la ST16 de olivo de Brasil y tiene menor similitud con la ST53 CoDiRo, presente en olivares de Italia causando la enfermedad denominada decaimiento súbito del olivo (Olive Quick Decline Syndrome-OQDS).
Es fundamental continuar con la identificación de más aislamientos por la posibilidad de encontrar diferentes ST de X. fastidiosa en otras zonas de plantaciones de olivos de nuestro país.
Es importante destacar que a partir de un aislamiento local fue posible elaborar un antisuero policlonal AsXf4 que permite la implementación de reactivos de diagnóstico serológicos para la detección de X. fastidiosa en olivo y en otras especies vegetales. Además, posibilita el testeo de una mayor cantidad de muestras, en menor tiempo y lo más económicamente posible, facilitando la toma inmediata de medidas de exclusión, en aquellas áreas donde todavía no se encuentra establecida la bacteria.
Mediante DAS ELISA, el AsXf4 reconoció a X. fastidiosa con adecuada sensibilidad y alta especificidad y no reaccionó frente a otras bacterias patógenas de plantas, en particular bacterias que afectan olivo, excepto una leve reacción cruzada con E. amylovora. Además, se determinó que a mayores tiempos de incubación (2 h de reacción) este antisuero tendría un mejor comportamiento que a la hora, equiparándose con el kit comercial. Respecto a este último, se observó coloración en los testigos sanos, aumentando sus valores de absorbancia a las dos horas, sin embargo no sucedió lo mismo con el AsXf4, donde los testigos sanos se mantuvieron incoloros. Se estandarizó una dilución de uso del AsXf4 de 1/200 para IgG y conjugado, y se considera que a las dos horas de colocado el sustrato sería el momento más apropiado para evaluar los valores de lectura de absorbancia, pudiéndose continuar con estas mientras los testigos sanos permanezcan estables. Dado que en las pruebas de diagnóstico realizadas en olivo se observó que existe inhibición, se sugiere macerar el tejido vegetal en diluciones de al menos 1/30 (p/v) para evitar falsos negativos. Además, este antisuero policlonal elaborado a partir de una cepa local permitió detectar diferentes subespecies de X. fastidiosa en distintos hospedantes.
AsXf4 fue probado mediante DAS ELISA en el laboratorio del IVIA donde se evaluaron cuatro cepas de X. fastidiosa: una de la subespecie pauca de cafeto (CFBP 8072, Ecuador) y tres de la subespecie fastidiosa de almendro (LMG 15099, Florida, EUA), vid (LMG 17159, California, EUA) y cerezo (IVIA 5235, Islas Baleares, España). Las observaciones realizadas mostraron que estas cepas fueron reconocidas por el antisuero (Noales y Gorris, 2019, com. pers.), como sucede también empleando el kit comercial Agdia.
Otro aporte de importancia de los estudios realizados en este trabajo es permitir la utilización del reactivo en diferentes laboratorios de nuestro país donde se diagnostica este patógeno, sin tener el impedimento de no disponer de manera continua con reactivos serológicos. El Instituto de Patología Vegetal-IPAVE cuenta con la capacidad de producción de antisueros y teniendo cepas aisladas de esta bacteria se asegura su abastecimiento. Los reactivos comerciales importados, además de tener un alto costo están elaborados a partir de cepas extranjeras que podrían ser menos sensibles en la detección de la bacteria en el material vegetal analizado.
Como propuesta de trabajo sobre futuras líneas de investigación sería importante realizar interlaboratorios a nivel nacional e internacional con el reactivo AsXf4 para conocer su comportamiento en respuesta a la detección de diferentes hospedantes de X. fastidiosa además de olivo.
Agradecimientos
Este trabajo fue financiado por el Programa Nacional de Protección Vegetal del Instituto Nacional de Tecnología Agropecuaria (INTA).
Agradecemos a la Dra. Cecilia Luciani, al personal de apoyo Walter F. Arce y a las Téc. Lab. Valeria Quevedo y Soledad Brandimarte por sus aportes para este trabajo.
Agradecemos a la Dra. Ester Marco Noales y a la Dra. Teresa Gorris del laboratorio de bacteriología del IVIA de Valencia (España) por los ensayos realizados con el reactivo AsXf4.
BIBLIOGRAFÍA
BALL, E.M.; HAMPTON, R.O.; DE BOER, S.H.; SCHAAD, N.W. 1990. Polyclonal Antibodies. En: HAMPTON, R.; BALL, E.; DE BOER, S. (Eds.). Serological Methods for Detection and Identification of Viral and Bacterial Plant Pathogens. APS Press, St. Paul. 33-54 pp.
BARRANCO NAVERO, D.; CIMATO, A.; FIORINO, P.; RALLO, L.; TOUZANI A.; CASTAÑEDA, C.; SERAFINI, F.; TRUJILLO, I. 2000. Catálogo Mundial de Variedades de Olivo. Consejo Oleícola Internacional. Madrid. España. 360 p.
BRLANSKY, R.H.; DAVIS, C.L.; TIMMER, L.W.; HOWD, D.S.; CONTRERAS, J. 1991. Xylem limited bacteria in citrus from Argentina with symptoms of citrus variegated chlorosis. Phytopathology 81:1210.
CARIDDI, C.; SAPONARI, M.; BOSCIA, D.; DE STRADIS, A.; LOCONSOLE, G.; NIGRO, F.; PORCELLI, F.; POTERE, O.; MARTELLI, G. P. 2014. Isolation of a Xylella fastidiosa strain infecting olive and oleander in Apulia, Italy. Journal of Plant Pathology 96 (3), 1-5.
CARLUCCI, A.; LOPS, F.; MARCHI, G.; MUGNAI, L.; SURICO, G. 2013. Has Xylella fastidiosa “chosen” olive trees to establish in the Mediterranean basin? Phytopathologia Mediterranea 52 (3), 541-544.
CATALANO, L.; SHOKI, A.D.; BOSCIA, D.; MARTELLI, G. P. 2019. Guidelines for the prevention, eradication and containment of Xylella fastidiosa in olive-growing areas. [Series]. Cairo, Organización de las Naciones Unidas para la Alimentación y la Agricultura-FAO. 66 p.
CESBRON, S.; DUPAS, E.; BEAUREPÈRE, Q.; BRIAND, M.; MONTES-BORREGO, M.; VELASCO-AMO, M.; LANDA, B.B.; JACQUES, M. 2020. Development of a Nested-Multilocus Sequence Typing approach for a highly sensitive and specific identification of Xylella fastidiosa subspecies directly from plant samples. Agronomy, 1-17 pp. doi:10.3390/agronomy10081099
CLARK, M.F.; ADAMS, A.N. 1977. Characteristic of microplate method of enzyme linked immunosorbent assay for the detection of plant viruses. Journal of General Virology 34, 475-483.
COLETTA-FILHO, H.D.; FRANCISCO, C.S.; LOPES, J.R.S.; MULLER, C.; ALMEIDA, R.P.P. 2017. Homologous Recombination and Xylella fastidiosa host–pathogen associations in South America. Phytopathology. Ecology and Epidemiology 107, 305-312. doi.org/10.1094/PHYTO-09-16-0321-R
CONSEJERÍA DE AGRICULTURA, GANADERÍA, PESCA Y DESARROLLO SOSTENIBLE DE LA JUNTA DE ANDALUCÍA (CAGPDS-JA) 2020. Red de Alerta e Información Fitosanitaria de Andalucía (RAIF). Nuevos focos de Xylella fastidiosa en Portugal. (Disponible: http://www.juntadeandalucia.es/agriculturapescaydesarrollorural/raif/rss/-/asset_publisher/OpV27pD7buE7/content/id/4915022 verificado: 20 de octubre de 2020).
DAVIS, M.J.; PURCELL, A.H.; THOMSON, S.V. 1980. Isolation medium for Pierce`s disease bacterium. Phytopathology 70, 425-429.
DAVIS, M.J.; FRENCH, W.J.; SCHAAD, N.W. 1981a. Axenic culture of the bacteria associated with phony disease of peach and plum leaf scald. Current Microbiology 6, 309-314. doi.org/10.1007/BF01566883
DAVIS, M.J.; WHITCOMB, R.F.; GILLASPIE, A.G.J. 1981b. Fastidious bacteria of plant vascular tissue and invertebrates (including so called rickettsia-like bacteria). En: STARR, M.P.; STOLP, H.; TRUPER, H.G.; BALOWS, A.; SCHLEGEL, H.G.; (Eds.) The prokaryotes: a handbook on habits, isolation, and identification of bacteria. Berlin, Heidelberg: Springer-Verlag. 2172-2188 pp.
DE BENEDICTIS, M.; DE CAROLI, M.; BACCELLI, I.; MARCHI, G.; BLEVE, G.; GALLO, A.; RANALDI, F.; FALCO, V.; PASQUALI, V.; PIRO, G.; MITA, G.; DI SANSEBASTIANO, GP. 2017. Vessel occlusion in three cultivars of Olea europaea naturally exposed to Xylella fastidiosa in open field. Journal of Phytopathology 165, 589-594. doi: 10.1111/jph.12596
DANANCÉ, N.; BRIAND, M.; GABORIEAU, R.; GAILLARD, S.; MARIE-AGNÈS, J. 2019. Identification of genetic relationships and subspecies signatures in Xylella fastidiosa. BMC Genomics 20, 239. doi.org/10.1186/s12864-019-5565-9
DENANCÉ, N.; LEGENDRE, B.; BRIAND, M.; OLIVIER, V.; DE BOISSESON, C.; POLIAKOFF, F.; JACQUES, M.A. 2017. Several subspecies and sequence types are associated with the emergence of Xylella fastidiosa in natural settings in France. Plant Pathology 66, 1054-1064. doi: 10.1111/ppa.12695
ELBEAINO, T.; VALENTINI, F.; ABOU KUBAA, R.; MOUBARAK, P.; YASEEN, T.; DIGIARO, M. 2014. Multilocus sequence typing of Xylella fastidiosa isolated from olive affected by “olive quick decline syndrome” in Italy. Phytopathologia Mediterranea 53 (3), 533-542.
EUROPEAN COMMISSION. 2018. Xylella fastidiosa. (Disponible: https://ec.europa.eu/food/plant/plant_health_biosecurity/legislation/emergency_measures/xylella-fastidiosa_en verificado: 04 de agosto de 2019).
EPPO Bulletin 2018. Diagnostics. PM 7/24 (3) Xylella fastidiosa. European and Mediterranean Plant Protection Organization 48 (2), 175-218. doi: 10.1111/epp.12469.
FRANCIS, M.; LIN, H.; CABRERA-LA ROSA, J.; DODDAPANENI, H.; CIVEROLO, E.L. 2006. Genome-based PCR primers for specific and sensitive detection and quantification of Xylella fastidiosa. European Journal of Plant Pathology 115, 203-213.
FELSENSTEIN, J. 1985. Confidence limits on phylogenies: An approach using the bootstrap. Evolution 39, 783-791.
FRITSCHI, F.B.; LIN, H.; WALKER, M.A. 2008. Scanning electron microscopy reveals different response pattern of four Vitis genotypes to Xylella fastidiosa infection. Plant Disease. 92:276-286.
FUENTE DELGADO, S. 1990. Procedures. Curso avanzado de virología. Centro international de la papa (CIP), Lima, Perú. En: DOCAMPO, D.M.; LENARDON, S.L. (Eds.). Métodos para detectar patógenos sistémicos. Instituto de Fitopatología y Fisiología Vegetal IFFIVE-INTA-JICA, Córdoba, Argentina. 116 p.
GUTIÉRREZ HERNÁNDEZ, O.; GARCÍA, L.V. 2018. Incidencia de Xylella fastidiosa en las Islas Baleares y distribución potencial en la península ibérica. Investigaciones Geográficas (69), 55-72. doi.org/10.14198/INGEO2018.69.04
HAELTERMAN, R.M.; TOLOCKA, P.A.; ROCA, M.E.; GUZMÁN, F.A.; FERNÁNDEZ, F.D.; OTERO, M.L. 2015. First presumptive diagnosis of Xylella fastidiosa causing olive scorch in Argentina. Journal of Plant Pathology 97 (2), 393-393. doi:104454/JPP.V97I2.023
HAMMOND, J.; JORDAN, R. 1990. Dot Blots (Viruses) and Colony Screening. En: HAMPTON, R.; BALL, E.; DE BOER, S. (Eds.). Serological Methods for Detection an Identification of Viral and Bacterial plant Pathogens, A Laboratory Manual. APS Press, St. Paul, 237-248 pp.
KITAJIMA, E.W.; NOME, C.F. 1999. Microscopía electrónica en virología vegetal. En: DOCAMPO, D.M.; LENARDON, S.L. (Eds.). Métodos para detectar patógenos sistémicos. Instituto de Fitopatología y Fisiología Vegetal IFFIVE-INTA-JICA, Córdoba, Argentina. 75-77 pp.
LANDA, B.B.; NAVAS CORTÉS, J.A.; MONTES BORREGO, M. 2017. Capítulo 2: Características generales de X. fastidiosa. En: LANDA, B.B.; MARCO-NOALES, E.; LÓPEZ, M.M. (Coord.). Enfermedades causadas por la bacteria Xylella fastidiosa. Cajamar Caja Rural (ed.), España.47 p.
LANDA, B.B.; CASTILLO, A.I.; GIAMPETRUZZI, A.; KAHN, A.; ROMÁN-ÉCIJA, M.; VELASCO-AMO, M.P.; NAVAS-CORTÉS, J.A.; MARCO-NOALES, E.; BARBÉ, S.; MORALEJO, E.; COLETTA-FILHO, H.D.; SALDARELLI, P.; SAPONARI, M.; ALMEIDA, R.P.P. 2019. Emergence of a plant pathogen in Europe associated with multiple intercontinental introductions. Applied and Environmental Microbiology, doi: 10.1128/AEM.01521-19
LOCONSOLE, G.; POTERE, O.; BOSCIA, D.; ALTAMURA, G.; DJELOUAH, K.; ELBEAINO, T.; FRASHERI, D.; LORUSSO, D.; PALMISANO, F.; POLLASTRO, P.; SILLETTI, M.R.; TRISCIUZZI, N.; VALENTINI, F.; SAVINO, V.; SAPONARI, M. 2014. Detection of Xylella fastidiosa in olive trees by molecular and serological methods. Journal of Plant Pathology 96 (1), 1-8.
LOMMEL, S.A.; MCCAIN, A.H.; MORRIS, T.J. 1982. Evaluation of indirect enzyme- linked immunosorbent assay for the detection of plant viruses. Phytopathology 72, 1018-1022.
NOME, S.F.; HAELTERMAN, R.M.; DOCAMPO, D.M.; PRATA-VIERA, A.G.; DI FEO, L.DELV. 1992. Escaldadura de las hojas del almendro en Argentina. Fitopatología Brasileira 17, 57-60.
NUNNEY, L.; VICKERMAN, D.B.; BROMLEY, R.E.; RUSSELL, S.A.; HARTMAN, J.R.; MORANO, L.D.; STOUTHAMER, R. 2013. Recent evolutionary radiation and host plant specialization in the Xylella fastidiosa subspecies native to the United States. Applied and Environmental Microbiology 79 (7), 2189-2200. doi: 10.1128/AEM.03208-12
NUNNEY, L.; ORTIZ, B.; RUSSELL, S.A.; SÁNCHEZ, R.R.; STOUTHAMER, R. 2014. The complex biogeography of the plant pathogen Xylella fastidiosa: Genetic evidence of introductions and subspecific introgression in Central America. PLoS ONE. https://doi.org/10.1371/journal.pone.0112463
MACKENZIE, D.J. 1990. Preparation of Antibody-Enzyme Conjugates. En: HAMPTON, R.; BALL, E.; DE BOER, S. (Eds.). Serological Methods for Detection and Identification of Viral and Bacterial Plant Pathogens. APS Press, St. Paul. 87-92 pp.
MINSAVAGE, G.V.; THOMPSON, C.M.; HOPKINS, D.L.; LEITE, R.M.V.; STALL, R.E. 1994. Development of a polymerase chain reaction protocol for detection of Xylella fastidiosa in plant tissue. Phytopathology 84, 456-461.
MORENTE, M.; CORNARA, D.; PLAZA, M.; DURÁN, J.M.; CAPISCOL, C.; TRILLO, R.; RUIZ, M.; RUZ, C.; SANJUAN, S.; PEREIRA, J.A.; MORENO, A.; FERERES, A. 2018. Distribution and relative abundance of insect vectors of Xylella fastidiosa in olive groves of the Iberian Peninsula. Insects 9 (4). pii: E175. doi: 10.3390/insects9040175
MURRAY, M.G.; THOMPSON, W.F. 1980. Rapid isolation of high molecular weight plant DNA. Nucleic Acids Res. 8 (19), 4321-4325. PMCID: PMC324241.
PHYTOMA. 2020. La EFSA añade 37 nuevas especies al listado de plantas hospedantes de Xylella. (Disponible: https://www.phytoma.com/noticias/noticias-de-actualidad/la-efsa-anade-37-nuevas-especies-al-listado-de-plantas-hospedantes-de-xylella verificado: 28 de noviembre de 2020).
ROCA, M.E.; TOLOCKA, P.A.; OTERO M.L.; PÉREZ, J.C.; HAELTERMAN, R.M. 2014. Primera detección de Xylella fastidiosa en olivares en los departamentos Arauco y Castro Barros (La Rioja). iii Congreso Argentino de Fitopatología. 169 p.
SAITOU, N.; NEI, M. 1987. The neighbor-joining method: a new method for reconstructing phylogenetic trees. Molecular Biology Evolution 4 (4), 406-425.
SAPONARI, M.; BOSCIA, D.; NIGRO, F.; MARTELLI, G.P. 2013. Identification of DNA sequences related to Xylella fastidiosa in oleander, almond and olive trees exhibiting leaf scorch symptoms in Apulia (Southern Italy). Journal of Plant Pathology 95 (3), 659-668.
SAPONARI, M.; BOSCIA, D.; LOCONSOLE, G.; PALMISANO, F.; SAVINO, V.; POTERE, O.; MARTELLI, G.P. 2014. New hosts of Xylella fastidiosa strain CoDiRo in Apulia. doi: 10.4454/JPP.V96I3.008
SCALLY, M.; SCHUENZEL, E.L.; STOUTHAMER, R.; NUNNEY, L. 2005. Multilocus sequence type system for the plant pathogen Xylella fastidiosa and relative contributions of recombination and point mutation to clonal diversity. Applied and Environmental Microbiology 71 (12), 8491-8499.
SCHAAD, N.W.; POSTNIKOVA, E.; LACY, G.; FATMI, M.; CHANG, C.J. 2004. Erratum. Xylella fastidiosa subspecies: X. fastidiosa subsp. [correction] fastidiosa [correction] subsp. nov., X. fastidiosa subsp. multiplex subsp. nov., and X. fastidiosa subsp. pauca subsp. nov. Systematic and Applied Microbiology 27 (3) 290-300.
SCHUENZEL, E.L.; SCALLY, M.; STOUTHAMER, R.; NUNNEY, L. 2005. A Multigene Phylogenetic Study of Clonal Diversity and Divergence in North American Strains of the Plant Pathogen Xylella fastidiosa. Applied and Environmental Microbiology 71 (7), 3832-3839.
SICARD, A.; ZEILINGER, A.R.; VANHOVE, M. 2018. Xylella fastidiosa: insights into an emerging plant pathogen. Annual Review of Phytopathology 56, 181-202. doi.org/10.1146/annurev-phyto-080417-045849
TACCHINI, J. 2010. Historia del olivo y su difusión en Argentina y en Mendoza. En: BAUZÁ, M. (Ed.). Olivicultura en Mendoza. Raigambre de una actividad que se renueva, Fundación Marzano. 19-47 pp.
TAMURA, K.; STECHER, G.; PETERSON, D.; FILIPSKI, A.; KUMAR, S. 2013. MEGA6: Molecular Evolutionary Genetics Analysis version 6.0. Molecular Biology and Evolution 30, 2725-2729.
THOMPSON, J.D.; HIGGINS, D.G.; GIBSON, T.J. 1994. Clustal W: improving the sensitivity of progressive multiple sequence alignment through sequence weighting, position-specific gap penalties and weight matrix choice. Nucleic Acids Research, 22 (22), 4673-4680. doi.org/10.1093/nar/22.22.4673
TOLOCKA, P.A.; OTERO, M.L.; TORRES, L.; TABORDA, R.J.; HAELTERMAN, R.M. 2014. Detección de Xylella fastidiosa en huertos de olivo de la región noroeste de la provincia de Córdoba. xxxvii Congreso Argentino de Horticultura-ASAHO 33 (82), 103.
TOLOCKA, P.A.; MATTIO, M.F.; PACCIORETTI, M.A.; OTERO, M.L.; ROCA, M.E.; GUZMÁN, F.A.; HAELTERMAN, R.M. 2017a. Xylella fastidiosa subsp. pauca ST69 in olive in Argentina. Journal of Plant Pathology 99 (3), 799-818.
TOLOCKA, P.A.; MATTIO, M.F.; OTERO, M.L.; PACCIORETTI, M.D.; ROCA, M.E.; GUZMÁN, F.A.; HAELTERMAN, R.M. 2017b. Nueva secuencia tipo de Xylella fastidiosa subsp. pauca ST78, obtenida de un aislamiento de almendro de Argentina. iv Congreso Argentino de Fitopatología. Mendoza. 177 p.
TOLOCKA, P.A.; MATTIO, M.F.; OTERO, M.L.; PACCIORETTI, M.D.; ROCA, M.; GUZMÁN, F.A.; HAELTERMAN, R.M. 2017c. Xylella fastidiosa subsp. pauca ST69, detectada en cítricos argentinos. IV Congreso Argentino de Fitopatología. 180 p.
VON BACZKO, O.H.; AGUIRRE, F.; ROCA, M.E.; BATTAGLIA, M.J.; FLORES, F.; KRONEBERGER, E.; TOLOCKA, P.A.; PACCIORETTI, M.; HAELTERMAN, R.M. 2017. Monitoreo de Xylella fastidiosa en zonas olivícolas de Argentina. iv Congreso Argentino de Fitopatología. Mendoza. 168 p.
WELLS, J.M.; RAJU, B.C.; NYLAND, G.; LOWE, S.K. 1981. Medium for isolation and growth of bacteria associated with plum leaf scald and phony peach diseases. Applied and Environmental Microbiology 42 (2), 357-363.
WELLS, J.M.; RAJU, B.C.; HUNG, H.Y.; WEISBURG, W.G.; MANDECO, P.L.; BRENNER, D.J. 1987. Xylella fastidiosa gen. nov., sp. nov.: gram-negative, xylem-limited, fastidious plant bacteria related to Xanthomonas spp. International Journal of Systematic Bacteriology 37,136-143.
YUAN, X.; MORANO, L.; BROMLEY, R.; SPRING-PEARSON, S.; STOUTHAMER, R.; NUNNEY, L. 2010. Multilocus sequence typing of Xylella fastidiosa causing Pierce`s disease and oleander leaf scorch in the United States. Ecology and Epidemiology. Phytopathology 100 (6), 601-610.
